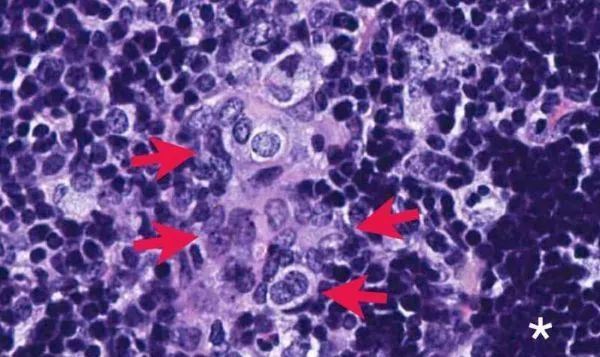
每日医健大事——2019年5月18日

TransMedics完成1.05亿美元IPO融资,其器官护理系统可延长移植器官体外保存时间

近日,TransMedics(纳斯达克股票代码:TMDX)完成完成了1.05亿美元IPO融资。该公司以每股16美元的价格发行了近570万股股票,此次 IPO还包括承销商认购的854000股股票的选择权,总收益为1.047亿美元(未扣除承销佣金和其他发行费用)。
摩根士丹利( Morgan Stanley )和摩根大通( J.P . Morgan )担任此次发行的联合账簿管理人,Cowen和Canaccord Genuity担任此次发行的联合经理。
据悉,TransMedics自1998年成立以来共筹集了2.59亿美元的资金,筹集资金回合数达到13次。最近两次融资在2016年5月和7月分别完成5120万美元和1250万美元融资。
TransMedics Group, Inc.于1998年8月在特拉华州注册,是一家医疗技术公司,为多种疾病状态的终末期器官衰竭患者提供转化器官移植疗法。该公司开发的器官护理系统(OCS)取代了数十年前的护理标准,OCS技术复制了器官在人体内的生存环境,以前的护理标准严重限制了全球数十万患者获得挽救生命的移植治疗效果。因此,OCS代表了一种技术转变,将移植的器官保存环境从静态转变为动态。
器官护理系统(OCS)是一种创新技术和多器官平台,可以改善移植患者的治疗效果,增加全球可移植器官的数量。OCS是唯一一种能够复制人体内器官活性生理条件的便携式保存技术,解决了冷藏技术的局限。
以前,从捐赠者体内取出的待移植心脏必须在4小时内移植给接受者,因为在传统低温保存环境下,心脏只能存活4小时。而TransMedics的“器官呵护系统”采用全新概念,使待移植心脏在无菌环境下运输,从而使心脏体外存活时间达到12小时。
OCS Lung获得FDA批准和CE认证,OCS Heart获得CE认证,正在接受FDA的审核,OCS Liver获得CE认证。这三种产品在美国、欧洲、澳大利亚和加拿大的主要移植中心进行商业或研究使用。
来源:动脉网
医疗数据公司BHE完成7800万美元融资,拓展其真实世界证据平台
2019年5月15日,医疗数据公司BHE完成7800万美元股权融资。本轮融资由Silversmith Capital Partners和Leerink Transformation Partners领投。这笔资金将用于加速开发其真实世界证据分析平台IHD,并拓展公司市场。
BHE成立于1996年,是一家总部位于美国马萨诸塞州的医疗数据公司。该公司致力于使用各种医疗数据源(包括电子健康记录)开展前沿研究,制定医疗保健干预措施和治疗策略,以降低医疗成本,提高医疗质量。
BHE的旗舰平台IHD是一个基于SaaS的真实世界证据平台。该平台能够帮助用户快速地分析20多种不同的现实世界数据库,包括医疗索赔、实验室试验结果、电子病历、医院数据等。
IHD具有分析速度快、灵活、直观的优点,即使用户不具备编程知识,也能对真实世界数据进行深度分析。以前用户需要数周或数月才能完成的研究分析,采用该平台可以在几天甚至几小时内完成。该平台推出以来,受到了科学研究人员、流行病学家、医生、统计学家、软件工程师的青睐,已成为医疗公司和其它研究组织的标准分析工具。目前,该平台正在被20多家生命科学公司和研究机构使用。
据了解,真实世界数据是指传统临床试验以外的数据,包括医疗从业者提供的电子医疗档案、健康档案、临床评估记录;患者社交网络的行为数据以及患者的结果研究数据;医药企业提供的市场营销数据、研发数据;医保机构持有的报销数据等。这些数据共同构成了真实世界数据。研究人员通过分析这些数据得出的与医疗产品的使用及潜在获益或风险相关的临床研究证据被称为真实世界证据。
长久以来,药物上市前,研究人员会通过随机抽样的方式在特定的人群中进行临床试验,以保证药物的安全性和有效性。但是药物上市后,可能出现药物的实际疗效和临床试验结果不一致的情况。收集和分析真实世界数据,可以真实、全面地反应该药物在实际运用过程中的情况,帮助研究人员做出更好的决策。
BHE首席技术官Jordan Menzin表示:“随着大数据技术和计算机技术的进步,以及生命科学公司和FDA的重视,真实世界证据在近几年得到了飞速发展。这笔融资将使我们不断进行产品创新,利用真实世界证据为患者开发新型治疗方案。”
来源:动脉网
Phil完成2500万美元B轮融资,推广特殊药品管理平台
特殊药品管理平台开发商Phil于5月15日宣布完成2500万美元B轮融资。此次融资由新投资方GreatPoint Ventures领投,Tarsadia Investments、Crosslink Capital和Uncork Capital跟投。这笔资金将重点用于招聘技术人才和扩大业务范围,以推动公司发展。
Phil开发了目前唯一一个专门销售和管理处方药的端到端健康技术平台,通过构建现代化的特殊药品分销网络将患者、处方者、药房和制造商联系起来,旨在降低沟通成本,让医生专注于患者护理,改善病人的治疗效果。
特殊药品是指用于治疗复杂疾病(如风湿性关节炎和艾滋病),并受到比其它药品更严格管制的药物。在当今世界,医生、药房工作人员以及服用特殊药物的患者都困于低效率的沟通模式和人工工作流程。医疗成本持续上涨,而治疗结果却不尽人意。基于此,Phil研发的处方管理平台提供了全面的解决方法,通过建立现代化药物网络消除医患和药店人员的痛点。Phil认为,不能仅针对药物网络中的某一方来解决药物管理问题。
Phil创始人兼首席执行官Deepak Thomas表示:“Phil提供了系统性解决方案。特殊药品管理问题不仅存在于制药行业,包括处方医生和制造商在内的其他利益相关者也同样面临着这些问题,而Phil的目标是从总体上解决这些问题。我们很高兴能与GreatPoint Ventures、Tarsadia Investments等公司进行合作,让医疗行业为此受益。”
虽然按数量计算,特殊药品只占处方药物的一小部分,但其管理成本极其高昂。Phil致力于通过提高分销特殊药品的工作效率,降低处方药成本。
GreatPoint Ventures合伙人Andrew Perlman表示:“医疗行业和制药供应链迫切需要现代化。GreatPoint很高兴能支持Phil开发特殊药品分销和管理的新方法,Phil平台使患者能够以更低的价格便利地购买药物。”
Phil正处于快速发展阶段,2018年其收入增长了15倍,预计还将呈指数级增长。公司团队去年有3个办公地点的规模扩大了两倍。该公司目前已建立了覆盖美国主要州的药物网络, 用户包括36000多名处方医生、他们的病人和主要的独立药店。
该平台的自动化特点简化了用户的工作流程——医生可对处方进行端到端的可视化管理,工作效率得到提高;独立药店也因此提高了运作效率;制造商的分销模式更能适应客户,订单完成率提高,总体销售成本降低。
来源:动脉网
Pulmonx完成6500万美元融资,开发微创设备治疗肺气肿,汇桥资本领投

近日,医疗器械公司Pulmonx完成6500万美元融资。本轮融资由汇桥资本(Ally Bridge Group)领投,RTW Investments、Driehaus Capital Management、ArrowMark Partners跟投。
Pulmonx总裁兼首席执行官Glen French表示:“汇桥资本成功地投资了许多医疗器械公司,我们很高兴能与其合作。这笔融资将用于加快推进公司产品的商业化,增加收入。”融资完成后,汇桥资本的合伙人兼医疗器械主管Charles Chon将加入Pulmonx董事会担任董事。
Pulmonx成立于1998年,总部位于美国加利福尼亚州红木城,是一家医疗器械公司。该公司专注开发创新微创医疗器械和技术,以改善慢性阻塞性患者的生活质量。
Crunchbase显示,Pulmonx累计完成8轮融资,融资金额超过1.6亿美元。其中,2010年3月,该公司曾完成由Kleiner Perkins和HealthCap领投的3200万美元融资;2007年5月,该公司曾完成由DeNovo Ventures领投的2000万美元B轮融资。
Pulmonx的主要产品Zephyr Valve是首款被FDA批准用于治疗严重肺气肿患者的微创设备。该产品是一种支气管内瓣膜植入物。医生将支气管镜通过鼻子或嘴插入患者肺部,并在气道放置3至5个Zephyr Valve。治疗时间约为30至60分钟。
Zephyr Valve可以缩小肺部病变部位的体积,改善肺部较健康部位发挥功能的能力,使患者呼吸更轻松。传统的治疗方法不可逆,设备植入后不可取出。但是在必要时,Zephyr Valve可以被取出体内。同时,该产品具有缓解患者症状,改善其活动能力的作用。
自2007年以来,全球已有超过15000万患者使用Zephyr Valve进行治疗。Zephyr Valve被全球领先的健康组织添加进肺气肿治疗指南中,包括慢性阻塞性肺病全球倡议组织(GOLD)和英国国家健康与护理卓越研究所(NICE)。
据了解,肺气肿是指终末细支气管远端(呼吸细支气管、肺泡管、肺泡囊和肺泡)的气道弹性减退,过度膨胀、充气和肺容积增大或伴有气道壁破坏的病理状态,具有致残、致死风险。肺气肿患者会感觉疲惫、呼吸不畅,即使是进行日常活动也会气喘吁吁。在美国有数百万肺气肿患者,这些患者的治疗选择较少,对微创和无创治疗方案有着巨大需求。
来源:动脉网
中南大学湘雅二医院护理团队自主研发一种按压止血器

外周静脉穿刺拔针后,部分人群无法对穿刺伤口进行持续有效的自主按压,容易导致穿刺伤口出血和皮下淤青,如:幼年儿童患者、上肢残缺患者、上肢瘫痪患者、行动不便的老年患者、病危患者、大型手术患者、全身麻醉患者、呼吸心脏骤停等患者。在重症监护室,患者在外周静脉穿刺后需要医护人员进行创口的持续按压5-15分钟,凝血功能障碍患者所需按压时间则更长,增加了医护人员的操作时间。为了能有效的保护好血管,解决静脉穿刺拔针后按压不方便,操作时间长等问题,中南大学湘雅二医院护理科研团队从外周静脉血管穿刺后创口的按压时间,按压压力和按压面积为基础研究,并充分考虑临床一线工作人员的操作便利性,经过7年的时间,成功研制一种通过力学原理持续按压静脉穿刺伤口的保护方法。
来源:健康界
Science:大脑齿状回中新生的神经细胞以两种方式影响年老的神经细胞

在一项新的研究中,来自美国哥伦比亚大学和纽约城市大学等研究机构的研究人员报道在大脑齿状回中新产生的神经细胞以两种方式影响年老的神经细胞。相关研究结果发表在2019年5月10日的Science期刊上,论文标题为“Adult-born hippocampal neurons bidirectionally modulate entorhinal inputs into the dentate gyrus”。在这篇论文中,这些研究人员描述了他们在小鼠模型中对神经发生的研究以及他们从中学到了什么。针对这项新的研究,西班牙塞韦罗-奥乔亚分子生物学中心的María Llorens-Martín在同期Science期刊上发表了一篇评论类型的文章。
神经科学家们近期才发现成年哺乳动物神经发生存在的证据,而且如今正在开展旨在了解更多信息的研究。在这项新的研究中,这些研究人员试图更多地了解神经发生在记忆和情绪中的作用。为此,他们利用转基因小鼠模型通过光遗传学和对海马体不同部位的电物理学记录进行了多项研究。通过这样做,他们发现齿状回中成熟神经元的行为受到附近新生神经元的行为的影响。他们还发现,这些新生神经元的行为似乎受到来自内嗅皮质(位于内侧颞叶)的信号的控制。
更具体地说,这些研究人员发现,新生成的神经元---他们称之为成体新生颗粒细胞(adult-born granule cell, abGC)---依赖于从内嗅皮质的两个部分之一接收的信号,以不同的方式作出表现。他们解释道,如果abGC从外侧内嗅皮层接收到信号,那么它们会抑制它们附近的更为成熟的神经细胞的活动。但是,如果它们从内侧内嗅皮层接收信号,它们会做相反的事情,激发年老的神经细胞。
这些研究人员指出,他们的研究结果表明,abGC的功能似乎是对内嗅皮层信号---已知来自外侧内嗅皮层的那些信号参与处理上下文信息,而来自内侧内嗅皮层的那些信号更多地参与处理空间信息---进行调节。Llorens-Martín建议,更多地了解这个过程如何受到微调应该有助于更好地理解对这个不断变化的系统的调节。
来源:生物谷
JCB:科学家鉴别出转移性前列腺癌的潜在治疗靶点
近日,一项刊登在国际杂志Journal of Cell Biology上的研究报告中,来自威尔康乃尔医学院等机构的科学家们通过研究发现,利用靶向作用PHLPP2蛋白的药物来治疗前列腺癌或许能够抑制癌细胞扩散到机体其它器官中,抑制PHLPP2或能降低MYC的水平,而MYC是一种引发多种类型癌症的致癌蛋白,其目前并不能被常规的药物疗法所靶向作用。
MYC是一种强大的癌基因,因为其能驱动细胞生长增殖并增强细胞的代谢和生存,据估计,在美国每年有大约45万人会被诊断为MYC所驱动的一种癌症;其中一种与MYC水平升高相关的癌症类型就是转移性前列腺癌,据美国癌症协会数据显示,大约九分之一的男性会在其一生中的某个时刻被诊断为前列腺癌,这种癌症是引发美国男性因癌症死亡的第二大原因,2019年预计会引发3万多男性患者死亡,大部分的患者死亡都是因为癌症扩散或转移所致。
研究者Lloyd C. Trotman教授表示,转移性前列腺癌患者的5年生存率仅为28%,而前列腺局限性疾病患者的5年生存率则几乎达到了99%。在转移性前列腺癌细胞中PHLPP2蛋白质的水平会升高,PHLPP2是一种磷酸酶,其能从其它蛋白质中移除磷酸基团,但目前研究者并不清楚该蛋白在前列腺癌发生过程中扮演的关键角色,这项研究中,研究者通过研究发现,前列腺癌细胞需要PHLPP2才能得以生存和增殖,而且PHLPP2能够通过移除磷酸基团来稳定MYC,凑则则会诱发MYC破坏。
研究者从小鼠机体中剔除了Phlpp2基因,结果发现,剔除该基因后会抑制前列腺癌细胞转移到机体其它器官中,这就很重要了,因为研究人员目前还不能开发出直接抑制MYC的疗法,因为其并没有含有被药物靶向作用的任何特征。随后研究者转向对人类前列腺癌细胞进行研究,研究者利用抑制PHLPP2的药物来处理前列腺癌细胞,随后发现,MYC的水平降低了,而且细胞也开始停止增殖开始死亡了。
研究者Trotman说道,PHLPP2在健康细胞中似乎并没有发挥任何必要的功能,因此这种酶类或许是一种有吸引力的靶点,其能帮助研究者间接靶向作用转移性前列腺癌或其它癌症中的MYC。本文研究结果表明,设计出药理学相关的PHLPP2*制剂抑**或许有望帮助有效抑制MYC驱动的癌症进展。
来源:生物谷
Mol Cell:重磅!首次发现氧化性压力会缩短端粒加速机体细胞衰老

被认为会对细胞造成氧化性压力的同样来源—污染、废气、吸烟和肥胖都与细胞端粒缩短有关,端粒是染色体末端的“保护帽”,近日,一项刊登在国际杂志Molecular Cell上的研究报告中,来自匹兹堡大学的科学家们通过研究首次确定氧化性压力或会直接对端粒产生影响来加速细胞衰老。
研究者Patricia Opresko教授表示,端粒由数百个鸟嘌呤碱基组成,而这些碱基正是用于氧化的“水槽”,那么这只是一个巧合吗?或者说在端粒中氧化这些鸟嘌呤是否真的会缩短端粒?为了解答这些问题,研究人员就需要找到方法来发现端粒所遭受的氧化性压力。文章中,研究人员开发了一种新方法,其能利用特殊的光激活分子来瞄准端粒,这种分子能附着在端粒上并根据指令运输局部的自由基团,这些自由基就是氧化性压力的分子。
研究者Bruchez说道,针对活细胞*特中**定位点的氧化性损伤的主要挑战之一就是如何实现这种损伤部位的精准时间和剂量的控制,通过将靶向端粒与单线态氧的光化学产生技术相结合,研究者就能够选择性地控制在端粒位点上特异性施加氧化性压力的时间和方式;随后研究者不断重复地将培养中的癌细胞暴露于靶向性的氧化步骤中,这就模拟了环境氧化性压力和炎症的状况,结果表明,随着细胞分裂,细胞中的端粒会破碎且缩短,尽管端粒酶发挥了一定的修复功能。
随着DNA修复机器试图开始修复破碎的端粒,染色体的末端也会经常融合在一起,从而使得基因组变得不稳定且会抑制细胞进行正常分裂。细胞中端粒缩短对于机体健康而言并不是个好消息,从另一方面来讲,靶向端粒或许能提供一种抗癌新策略。但若端粒足够短的话,癌细胞就会停止分裂。
最后研究者Opresko表示,如果我们能够理解引发端粒缩短的原因并去及时弥补的话,我们或许就有望开发出新型干预策略来保护健康细胞中的端粒,并促进癌细胞中端粒快速缩短,从而引发癌细胞死亡。
来源:生物谷